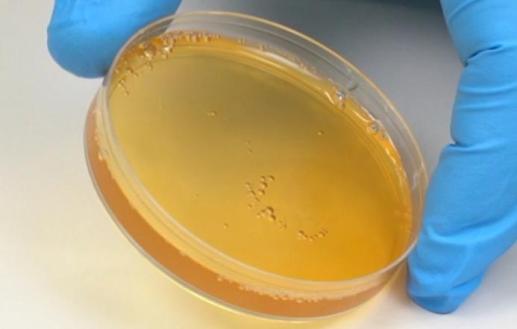

Wound Healing Treatment
By drawing a small amount of the patient's own blood and utilizing patented filtration and centrifugation techniques, AHC PRP—rich in growth factors, functional platelets, and plasma proteins—is extracted.
When this PRP is combined with Autologous Thrombin Serum (ATS), it forms a flexible, moldable autologous platelet gel. This gel conforms perfectly to wound surfaces of various shapes, providing a sustained release of repair factors to the site.
The Four Stages of Tissue Regeneration
Through PRP prolotherapy injections or gel application, the healing process undergoes the following biological transformations:
1. Modulation of the Inflammatory ResponseDuration:
Within hours to days. Sets the foundation for healing by regulating the initial inflammatory environment and clearing debris.
2. Angiogenesis (Vascularization) Role of VEGF:
Vascular Endothelial Growth Factor (VEGF) stimulates the restoration of blood flow, delivering essential oxygen and nutrients to the
damaged area.
3. Cell Migration and ProliferationCellular Recruitment:
Attracts mesenchymal stem cells to the site, promoting their attachment and differentiation into mature, specialized tissue cells.
4. ECM Synthesis & RemodelingExtracellular Matrix (ECM) Formation:
Promotes collagen synthesis and the development of healthy granulation tissue, ultimately leading to successful wound closure and
structural remodeling.
-

Autologous Thrombin Activation
Extends the bioactivity of growth factors to achieve a long-acting mechanism.
Promotes fibrinogen aggregation to form a3D polymer scaffold. -

Exudate management
Effectively reduces the risk of infection and maintains a moist environment conduciveto healing.Active leucocytes are retained within the scaffold to help reduce the wound's bioburden -

Rapid Preparation
Requires only a small blood volume to complete preparation within 6 minutes, maximizingsurgical efficiency.Removes >98% of Red Blood Cells (RBCs), ensuring maximum purity.

